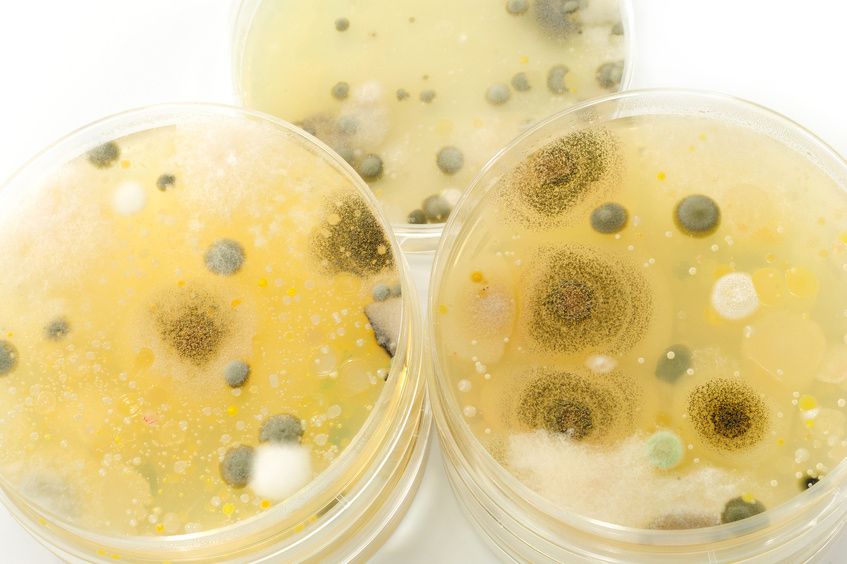

(Wien, 30-09-2016) Eine Forschungsgruppe der MedUni Wien hat Matrix-Assisted Laser Desorption/Ionisation Massenspektrometrie (MALDI-MS) zur Identifizierung von Pilzen und Hefekulturen eingesetzt. Als Alternative zum "Proteinbiotyping" wurde hier nun erstmalig das Potenzial der Verwendung von zellulären Lipidprofilen als Biomarker für die Charakterisierung von Hefen und Myzelpilzen ausgelotet ("MALDI Lipid Phenotyping").
Während MALDI-MS im Bereich der Identifizierung von Bakterien bereits routinemäßig eingesetzt wird, steckt deren Anwendung im Bereich der Pilzdiagnostik (z.B. Hefen und Myzelpilzen) noch in den Kinderschuhen. Unter Anwendung Multivariater Statistik und im Vergleich zu genotypischen Methoden konnte die Gruppe rund um Gerald Stübiger zeigen, dass die Lipidprofile eine Differenzierung naher verwandter Pilzstämme, die sich aufgrund bestimmter Lipidmoleküle unterscheiden, ermöglichen.
Matrix-Assisted Laser Desorption/Ionisation Massenspektrometrie (MALDI-MS) stellt eine robuste, empfindliche, kostengünstige und vielseitig anwendbare Analysenmethode dar. Ein Vorteil dieser Technik ist die Möglichkeit, gleichzeitig verschiedene Moleküle wie z.B. Proteine, Lipide, usw. aus biologischen Proben (z.B. Zellkultur, Gewebe, Körperflüssigkeiten, usw.) zu detektieren und so ein "Biomarkerprofil" zu erstellen. Dies macht MALDI-MS besonders für die klinischen Diagnostik attraktiv.
An der Universitätsklinik für Radiologie und Nuklearmedizin der MedUni Wien wird daran gearbeitet, diese Technik weiterzuentwickeln und an der MedUni Wien für diverse Anwendungen zu etablieren. „Ein entscheidender Schritt in diese Richtung ist uns im Jahr 2015 durch die Etablierung des ‚Labors für Klinische MALDI Anwendungen‘im Rahmen des K1-Zentrums für Biomarkerforschung in der Medizin (CBmed) gelungen, „erklärt Studienautor Gerald Stübiger, „in diesem Zusammenhang freuen wir uns, diese Arbeit aus dem Bereich der Mikrobiologie, die in Kooperation mit Kollegen der BOKU Wien und Firmenpartnern entstanden ist, zu präsentieren.“
2013 wurde MALDI-MS von der FDA (US Food and Drug Administration) als Methode für die rasche Identifizierung von Mikroorganismen als eigenständige Diagnosetechnik anerkannt und wird heute bereits von vielen Laboratorien im Bereich der klinischen Mikrobiologie eingesetzt. Es reicht dafür eine kleine Menge einer Bakterienkultur, die direkt auf einen Probenträger aufgetragen und in das Massenspektrometer eingeführt wird und mittels der Aufnahme eines charakteristischen Proteinprofils der Bakterienzellen zu deren Identifizierung herangezogen wird ("Protein Biotyping"). Die Aufnahme dauert dabei in der Regel weniger als eine Minute.
Breites Anwendungsgebiet
Während MALDI-MS im Bereich der Identifizierung von Bakterien bereits routinemäßig eingesetzt wird, steckt deren Anwendung für die Pilzdiagnostik noch in den Kinderschuhen. Ein Problem stellt dabei die komplexere Zellwandstruktur und post-translationale Modifikationen von Proteinen dar, die zu schlechteren Identifizierungsraten führen. Eine Optimierung der Probenpräparationstechnik ist daher erforderlich. Die Entwicklung neuer Methoden hat oft zu entscheidenden Durchbrüchen in der Diagnostik geführt. Als Alternative zum "Proteinbiotyping" haben die ForscherInnen nun erstmals das Potenzial der Verwendung von zellulären Lipidprofilen als Biomarker für die Charakterisierung von Hefen und Myzelpilzen (z.B. Saccharomyces, Penicillium, Aspergillus, Trichoderma, usw.) ausgelotet.
Membranlipide kommen sowohl in Pro- als auch Eukaryonten vor und stellen einen universellen Baustein aller zellulären Organismen dar. Sie erfüllen dort entscheidende Funktionen in der Zellorganisation und -regulation. In dieser Hinsicht zeigt die Methodik ein sehr breites Anwendungsgebiet auch über den Bereich der Mikroorganismen hinaus. Die Methode ist prinzipiell sehr einfach, erfordert für den Routineeinsatz aber die Einbindung von Software und die Entwicklung von Datenbanken für die automatisierte Datenanalyse. Um hier Fortschritte zu erzielen, sind weitere Forschungen mit Unterstützung von Firmenpartnern angestrebt.
Service: Journal of Microbiological Methods
Characterization of Yeasts and Filamentous Fungi using MALDI Lipid Phenotyping
Gerald Stübiger, Michael Wuczkowski, Luis Mancera, Ksenija Lopandic, Katja Sterflinger, Omar Belgacem, Journal of Microbiological Methods 130 (2016) 27–37.